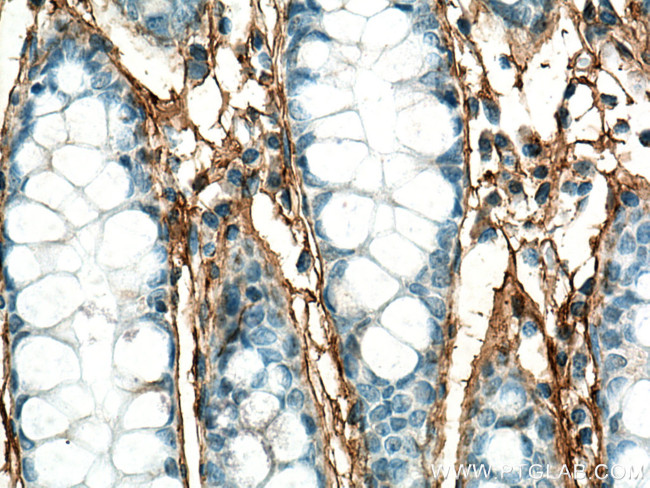
Periostin Antibody in Immunohistochemistry (Paraffin) (IHC (P))

Search
Proteintech
Periostin Polyclonal Antibody
{{$productOrderCtrl.translations['antibody.pdp.commerceCard.promotion.promotions']}}
{{$productOrderCtrl.translations['antibody.pdp.commerceCard.promotion.viewpromo']}}
{{$productOrderCtrl.translations['antibody.pdp.commerceCard.promotion.promocode']}}: {{promo.promoCode}} {{promo.promoTitle}} {{promo.promoDescription}}. {{$productOrderCtrl.translations['antibody.pdp.commerceCard.promotion.learnmore']}}
产品信息
27794-1-AP
种属反应
宿主/亚型
分类
类型
抗原
偶联物
形式
浓度
规格
纯化类型
保存液
内含物
保存条件
运输条件
产品详细信息
Aliquoting is unnecessary for -20°C storage.
靶标信息
Periostin (PN), also designated osteoblast-specific factor 2 (OSF-2), is a disulfide linked protein originally isolated as a osteoblast-specific factor. Periostin is a secreted protein that binds heparin and functions as a ligand for alpha(V)beta(3) and alpha(V)beta(5) integrins. In preosteoblasts, Periostin acts as a cell adhesion molecule and plays a role in osteoblast recruitment, spreading and attachment. Periostin is mainly detected in lower gastrointestinal tract, aorta, stomach, placenta, uterus and breast tissues but is up-regulated in epithelial ovarian tumors and overexpressed in breast cancer. Expression of Periostin is increased by bone morphogenetic protein (BMP2) and transforming growth factor beta 1(TGF beta 1). Periostin contains a typical signal sequence, followed by a cysteine-rich domain, a fourfold repeated domain, which shows homology with the insect protein fasciclin, and a C-terminal domain.
仅用于科研。不用于诊断过程。未经明确授权不得转售。
篇参考文献 (0)
生物信息学
蛋白别名: adhesion molecule; fasciclin I-like; Fasciclin-I like; MGC119510; MGC119511; OSF 2; OSF-2; osteoblast specific factor 2; osteoblast specific factor 2 (fasciclin I-like); Osteoblast-specific factor 2; periodontal ligament-specific periostin; Periostin; periostin, osteoblast specific factor; PN; RP11 412K4.1; RP11-412K4.1; unnamed protein product
基因别名: OSF-2; OSF2; PDLPOSTN; PN; POSTN
UniProt ID: (Human) Q15063
Entrez Gene ID: (Human) 10631